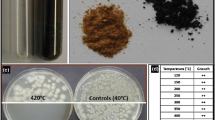

Abstract
RNA was extracted from dormant and germinating Bacillus subtilis 168 spores (intact spores and chemically decoated spores) by using rapid rupture followed by acid–phenol extraction. Spore germination progress was monitored by assaying colony forming ability before and after heat shock and by reading the optical density at 600 nm. The purity, yield, and composition of the extracted RNA were determined spectrophotometrically from the ratio of absorption at 260 nm to that at 280 nm; in a 2100 BioAnalyzer, giving the RNA yield/108 spores or cells and the distribution pattern of rRNA components. The method reported here for the extraction of RNA from dormant spores, as well as during different phases of germination and outgrowth, has proven to be fast, efficient and simple to handle. RNA of a high purity was obtained from dormant spores and during all phases of germination and growth. There was a significant increase in RNA yield during the transition from dormant spores to germination and subsequent outgrowth. Chemically decoated spores were retarded in germination and outgrowth compared with intact spores, and less RNA was extracted; however, the differences were not significant. This method for RNA isolation of dormant, germinating, and outgrowing bacterial endospores is a valuable prerequisite for gene expression studies, especially in studies on the responses of spores to hostile environmental conditions.
Similar content being viewed by others
Avoid common mistakes on your manuscript.
Because of their stability in harsh environments and their ease of transport and manipulation, spores of the Gram-positive bacterium Bacillus subtilis have been established as a powerful biodosimetric system for environmental monitoring and astrobiologic studies both in space flight and ground-based simulations [3, 8]. B. subtilis spores are highly resistant to inactivation by different physical stresses, such as toxic chemicals and biocidal agents, desiccation, pressure and temperature extremes, and high doses of radiation. Although spores are metabolically dormant, they respond to appropriate nutrients by their rapid germination and outgrowth into vegetative cells [8].
Environmental and astrobiological studies were originally concerned with the assessment of survival and mutagenesis of B. subtilis spores exposed to extreme environments prevailing on Earth, in space, or on other planets [8]. Recent attention has shifted toward understanding the molecular basis underlying spore survival against physical extremes. Since 1997, with the sequence of the genome of B. subtilis becoming available and annotated [5], comprehensive databases of B. subtilis genes and their functions have become available (for recent compilations see Minkovsky et al. [7] and http://genolist.pasteur.fr/Subtilist). This information has in turn spurred the development of whole-genome techniques for transcriptional profiling B. subtilis by using DNA microarrays [1, 4, 18]. The significance and reproducibility of DNA microarray experiments depend critically on the quality and purity of RNA extracted from cells. Until today, microarray experiments have included only RNA extracted from vegetative cells of B. subtilis. Extraction of intact RNA from Bacillus spp. spores poses special difficulties because spores possess thick layers of highly cross-linked coat proteins, modified peptidoglycan spore cortex, and abundant intracellular constituents, such as the calcium chelate of dipicolinic acid (Ca-DPA), as well as small, acid-soluble spore proteins (SASP) as protectants of spore nucleic acids [2, 16]. Problems in extraction of high-quality nucleic acid from spores can be traced to methods for spore disruption and enzymatic degradation. Spores are efficiently ruptured by physical agitation with glass beads [9], but this technique is harsh and leads to extensive shearing of both RNA and DNA [6, 10]. Intact chromosomal and plasmid DNA have been successfully isolated from chemically decoated spores [9, 10]. Extracting RNA from bacteria must be done carefully to avoid its enzymatic degradation by Rnases, which are ubiquitous, stable, and difficult to remove or inactivate. To address these issues, this article reports the development of a methodology for the rapid and simple extraction of high-quality total RNA from dormant and germinating spores of B. subtilis.
Materials and Methods
Microorganism, spore production and purification
B. subtilis 168 (DSM 402) was obtained from the German Collection of Microorganisms and Cell Cultures, Braunschweig, Germany. Spores were obtained by cultivation under vigorous aeration in Schaeffer sporulation medium containing (per litre) 16.0 g Difco nutrient broth (BD Diagnostics, Sparks, MD), 2.0 g KCl, and 0.7 g MgSO4 × 7H2O [13] for 4 days at 37°C until a sporulation frequency >90% had been reached as judged by phase-contrast microscopy. Sporulated cultures were harvested by centrifugation (10000 × g, 20 minutes, 4°C) and treated with MgSO4 (2.5 μg/ml), lysozyme (200 μg/ml), and DNAse I (2 μg/ml) for 30 minutes at 37°C to destroy the residual vegetative cells. The enzymes were inactivated by heating for 10 minutes at 80°C. After repeated centrifugation and washing in distilled water, the purified spores (approximately 1010 spores/ml) were stored in aqueous suspension at 4°C.
Decoating spores
To remove the spore coats, spores were centrifuged, resuspended in 10 ml 50 mM Tris-HCl (pH 8.0) containing 8 M urea, 1% sodium dodecyl sulfate, 10 mM ethylene diamine tetraacetic acid, and 50 mM dithiothreitol, and incubated for 90 minutes at 60°C as described in Riesenman and Nicholson WL [12]. After washing twice in phosphate-buffered saline (SAL) 0.7% Na2HPO4 × 2H2O, 0.3% KH2PO4, 0.4% NaCl; pH 7.5), the decoated spores (DEC) (approximately 1010/ml) were stored in SAL at 4°C.
Spore germination
Intact (INT) as well as DEC were subjected to germination as follows: 100 μl spore suspension (1010 spores/ml) was transferred into 250 ml 2 × LB (Luria-Bertani) medium containing 20.0 g Bacto-Tryptone, 10.0 g Bacto-Yeast extract (both from BD Diagnostics) and 10.0 g NaCl/l [14] plus 0.5 mM L-alanine, then incubated at 37°C under shaking (300 rpm). The germination profile was noted at 0, 30, 60, 90, and 120 minutes of incubation by determining (1) colony-forming units (CFUs), (2) survival (CFU) after heat treatment (10 minutes at 80°C), and (3) optical density (OD) at 600 nm. CFU was determined from 100-μl aliquots of the suspension plated on nutrient-broth-agar after appropriate dilutions in SAL and incubated overnight at 37°C. Experiments were repeated at least three times, and the data shown are mean plus SD. The germination curves of INT and DEC spores were compared statistically using Student t test. Differences with P values ≤0.05 were considered statistically significant.
RNA isolation and quantification
For RNA isolation, 25 ml of the culture was collected at the same time intervals as used for the determination of the germination and outgrowth profile. The samples, containing 108 spores during the germination phase or outgrowing cells, were centrifuged at 10000 × g for 5 minutes at 4°C, and the pellet was stored at –80°C until RNA isolation and analysis. RNA was isolated by the acid—phenol method, as described, by a modified FastPrep protocol (QbioGene, MP Biomedicals). RNA extraction was performed at either 4°C or on ice. The frozen pellet was resuspended in 400 μl SAL containing RNAlater (Qiagen, Duesseldorf, Germany) and transferred to a Lysing Matrix Tube B containing 0.1 mm silica spheres and 800 μl acid–phenol solution (Carl Roth GmbH, Karlsruhe, Germany). The Lysing Matrix Tube was then shaken in the FastPrep Instrument (Eubio, Austria) for 45 seconds at setting 6.5, removed, and centrifuged in a microfuge (12000 × g for 5 minutes at 4°C). During all extracting and washing steps, the upper phase, containing the RNA, was handled carefully to avoid transferring the debris- and DNA-containing pellets. The upper phase was transferred to an RNase-free 1.5-ml microcentrifuge tube containing 800 μl acid phenol solution, shaken by hand for 60 seconds, and centrifuged (12000 × g for 5 minutes at 4°C). The upper phase was then transferred to a clean microcentrifuge tube containing 800 μl chloroform/isoamyalcohol (v:v 96:4), shaken again, and centrifuged as previously indicated. The upper phase was transferred to a clean microcentrifuge tube and RNA precipitated by addition of 70 μl 3 M sodium acetate (pH 5.2) and 1 ml isopropanol (for 60 minutes at –80°C) followed by centrifugation (12000 × g for 5 minutes at 4°C). The pellet was washed with 1 ml ethanol, air dried for 5 minutes, resuspended in 30 μl RNase-free H2O (Invitrogen, Paisley, Scotland, UK) and stored at –80°C. The purity of the RNA preparation was assayed spectrophotometrically from the 260 nm/280 nm ratio by two commercial methods: NanoDrop (NanoDrop, Wilmington, DE), using undiluted RNA preparation, and GeneQuant (Biochrom, Cambridge, UK) using a 1:10 dilution in RNase-free H2O. A ratio between 1.8 and 2.0 is an indication of high-quality RNA with little or no contamination by proteins [17]. The amount of extracted RNA was normalized to the number of viable spores or cells per sample, as determined by CFU, and given as μg/108 spores or cells. The yield of the extracted RNA and intactness of rRNA was assayed from 1 μl diluted (1:10) RNA solution in a 2100 BioAnalyzer using the protocol of the RNA 6000 Nano Lab Chip Kit (Agilent, Böblingen, Germany).
Results and Discussion
Germination profile of INT and DEC spores
In this study, we discovered an efficient method for extracting intact RNA from endospores of B. subtilis for gene-expression experiments using dormant spores as well as germinating and outgrowing spores. Because chemically decoated spores have been reported to facilitate the extraction of DNA [9], they were also expected to facilitate the isolation of RNA. Therefore, first the germination profiles of both spore systems, INT and DEC, were compared (Fig. 1). A typical spore germination profile is shown for the INT spores characterized (1) by a nearly exponential decrease in the CFU of heat-treated samples, reflecting the progressive loss of spore integrity (this is indicated by the loss of heat resistance during germination); (2) by a decrease in OD during the first hour of incubation, which was caused by the excretion of spore components, such as Ca-DPA, and by spore core hydration [14, 15], which was then followed by an increase in OD as a consequence of spore outgrowth and subsequent cellular growth; and (3) by an increase of CFU after approximately 90 minutes of incubation, indicating the initiation of cell replication and subsequent cell division. This germination profile of INT spores is in good agreement with published data about B. subtilis spore germination and outgrowth [15]. The statistical comparison of the three curve types (CFU, OD, and heat resistance) did not give a significant difference between those of the INT and the DEC spores.
Although the germination profiles of INT and DEC spores are not statistically significant, germination of DEC spores was slightly delayed compared with that of INT spores, and the outgrowth was less efficient as judged by the OD values at 120 minutes. This retardation in germination and outgrowth may have been caused by potential destruction, damage, or inhibition of essential germination receptors [11, 15] during the chemical removal of spore coats.
Efficiency of RNA extraction from INT and DEC spores
RNA was extracted from INT and DEC spores at the following time intervals during germination: from dormant spores at 0 minutes of incubation, from germinating spores at 30 and 60 minutes of incubation, and from outgrowing spores at 90 and 120 minutes of incubation. The purity of the RNA preparation was assessed spectrophotometrically from the ratio of absorption at 260 nm to that at 280 nm. All preparations were of high RNA purity as indicated by a ratio in the range of 1.78 to 2.05, determined by the NanoDrop method, and of 1.73 to 2.04, determined by the GeneQuant method. There was no difference in the purity of RNA from INT and DEC spores.
The amount of extracted RNA depended on the status of the spores, i.e., whether they were dormant, germinating, and outgrowing (Fig. 2). It is interesting to note that with the method applied, it was possible to extract RNA of high purity from dormant spores (at 0 minutes of incubation), although the yield was rather low (1 to 2 μg RNA was isolated from 108 dormant spores). There was no statistically significant difference in the amount of RNA, whether it was extracted from dormant INT or DEC spores. The yield of extracted RNA per 108 INT spores doubled after 30 minutes of incubation. This increase in the amount of RNA extracted may be based on two processes: (1) the increasing susceptibility of the spore envelope to lysis during germination and (2) the initiation of RNA synthesis [15]. For INT spores, further duplications of the RNA yield were achieved after 90 minutes and again after 120 minutes of incubation. As followed from the CFU and OD data (Fig. 1), at these periods of incubation, growth and cell replication had already started. For DEC spores, the increase in the amount of extracted RNA with incubation time was less pronounced, although the differences in both curves (INT and DEC in Fig. 2) are not statistically significant at most time points. The amount of extracted RNA of both spore types were almost identical from 0 to 60 minutes of incubation. Between 90 and 120 minutes, the outgrowing INT spores showed approximately 1.5 to 2 times more extractable RNA than the outgrowing DEC spores. The final yield of RNA after 120 minutes of incubation was approximately 7 ± 1.5 μg/108 cells for DEC spores, whereas this value was approximately 11 ± 2.7 μg/108 cells for INT spores. For comparison, RNA isolation from vegetative B. subtilis cells performed by common commercial RNA extraction kits (i.e., Qiagen RNeasy Protect Bacteria Mini Kit, Duesseldorf, Germany) yielded in 10 to 20 μg RNA/108 cells.
The RNA from both INT and DEC spores was separated in a 2100 BioAnalyzer (Fig. 3). In all cases, densitometric tracings of the gel images showed that 16S and 23S rRNA species were represented by sharp main peaks at 39 and 42 seconds of retention time, respectively. The 5S rRNA peak was visible at 25 seconds of retention time. Densitometric traces of the images (Fig. 3) showed that rRNA peaks were sharp and nondegraded. In addition, several distinct minor peaks presumably representing individual mRNA species were also observed in the original gel, such as images (not shown) demonstrating the high quality of the extracted RNA. Spectrophotometric and densitometric quantification evidenced that the isolated RNA was pure and free from cellular substances, i.e., DNA, proteins, major inhibitors of subsequent molecular analysis.
The data show that the acid–phenol method used in this study is efficient to extract RNA from dormant bacterial endospores as well as germinating and outgrowing spores. As judged from the yield of rRNA, an amount of 108 spores is likely sufficient mRNA for further studies, such as gene expression analyses. Although chemically decoated spores have been reported to have the advantage of easier access to DNA [9], our studies did not show a higher extraction efficiency of RNA from DEC spores compared with INT spores. On the contrary, the germination efficiency, as well as the efficiency of RNA extraction, was impaired at all stages of germination of DEC versus INT spores, although the differences were not statistically significant. Follow-on experiments of the gene expression pattern during spore germination, using the procedure of RNA isolation described here, have shown significant differences in the gene expression of INT and DEC spores (Moeller et al., in preparation).
Literature Cited
Berka RM, Cui X, Yanofsky C (2003) Genomewide transcriptional changes associated with genetic alterations and nutritional supplementation affecting tryptophan metabolism in Bacillus subtilis. Proc Natl Acad Sci U S A 100:5682–5687
Driks A (1999) Bacillus subtilis spore coat. Microbiol Mol Biol Rev 63:1–20
Horneck G, Mileikowsky C, Melosh HJ, Wilson JW, Cucinotta FA, Gladman B (2002) Viable transfer of microorganisms in the solar system and beyond. In: Horneck G, Baumstark-Khan C (eds) Astrobiology: The quest for the conditions of life. New York, NY: Springer-Verlag, pp 57–76
Koburger T, Weidezahn J, Bernhardt J, Homuth G, Hecker M (2005) Genome–wide mRNA profiling in glucose starved Bacillus subtilis cells. Mol Genet Genomics 274:1–12
Kunst F, Ogasawara N, Moszer I, Albertini AM, Yoshikawa H, Danchin A, et al. (1997) The complete genome sequence of the gram-positive bacterium Bacillus subtilis. Nature 390:249–256
Mason JM, Fajardo-Cavazos P, Setlow P (1988) Levels of mRNAs which code for small, acid-soluble spore proteins and their lacZ gene fusions in sporulating cells of Bacillus subtilis. Nucleic Acids Res 16:6567–6583
Minkovsky N, Zarimani A, Chary VK, Johnstone BH, Powell BS, Torrance PD, et al. (2002) Bex, the Bacillus subtilis homolog of the essential Escherichia coli GTPase Era, is required for normal cell division and spore formation. J Bacteriol 184:6389–6394
Nicholson WL, Munakata N, Horneck G, Melosh HJ, Setlow P (2000) Resistance of bacterial spores to extreme terrestrial and extraterrestrial environments. Microbiol Mol Biol Rev 64:548–572
Nicholson WL, Setlow P (1990a) Dramatic increase in the negative superhelicity of plasmid DNA in the forespore compartment of sporulating cells of Bacillus subtilis. J Bacteriol 172:7–14
Nicholson WL, Setlow P (1990b) Sporulation, germination, and outgrowth. In: Harwood CR, Cutting SM (eds) Molecular biological methods for Bacillus. Sussex, UK: Wiley, pp 391–450
Paidhungat M, Setlow P (2001) Localization of a germinant receptor protein (gerba) to the inner membrane of Bacillus subtilis spores. J Bacteriol 183:3982–3990
Riesenman P, Nicholson WL (2000) Role of spore coat layers in Bacillus subtilis spore resistance to hydrogen peroxide, artificial UV-C, UV-B, and solar UV radiation. Appl Environ Microbiol 66:620–626
Schaeffer P, Millet J, Aubert JP (1965) Catabolic repression of bacterial sporulation. Proc Natl Acad Sci U S A 54:704–711
Setlow B, Setlow P (1996) Role of DNA repair in Bacillus subtilis spore resistance. J Bacteriol 178:3486–3495
Setlow P (2003) Spore germination. Current Opinion Microbiol 6:550–556
Setlow P, Hayes CS (2001) An alpha/beta-type, small, acid-soluble spore protein which has very high affinity for DNA prevents outgrowth of Bacillus subtilis spores. J Bacteriol 183:2662–2666
Sung K, Khan SA, Nawaz MS, Khan AA (2003) A simple and efficient Triton X-100 boiling and chloroform extraction method of RNA isolation from Gram-positive and Gram-negative bacteria. FEMS Microbiol Lett 229:97–101
Ye RW, Tao W, Bedzyk L, Young T, Chen M, Li L (2000) Global gene expression profiles of Bacillus subtilis grown under anaerobic conditions. J Bacteriol 182:4458–4465
Acknowledgments
The authors thank Joerg Angermann and Ina Wagner (MPI-IB, Berlin, Germany) for their help during RNA quantification. These results will be included in the doctoral thesis of R. Moeller.
Author information
Authors and Affiliations
Corresponding author
Rights and permissions
About this article
Cite this article
Moeller, R., Horneck, G., Rettberg, P. et al. A Method for Extracting RNA from Dormant and Germinating Bacillus subtilis Strain 168 Endospores. Curr Microbiol 53, 227–231 (2006). https://doi.org/10.1007/s00284-006-0099-1
Received:
Accepted:
Published:
Issue Date:
DOI: https://doi.org/10.1007/s00284-006-0099-1